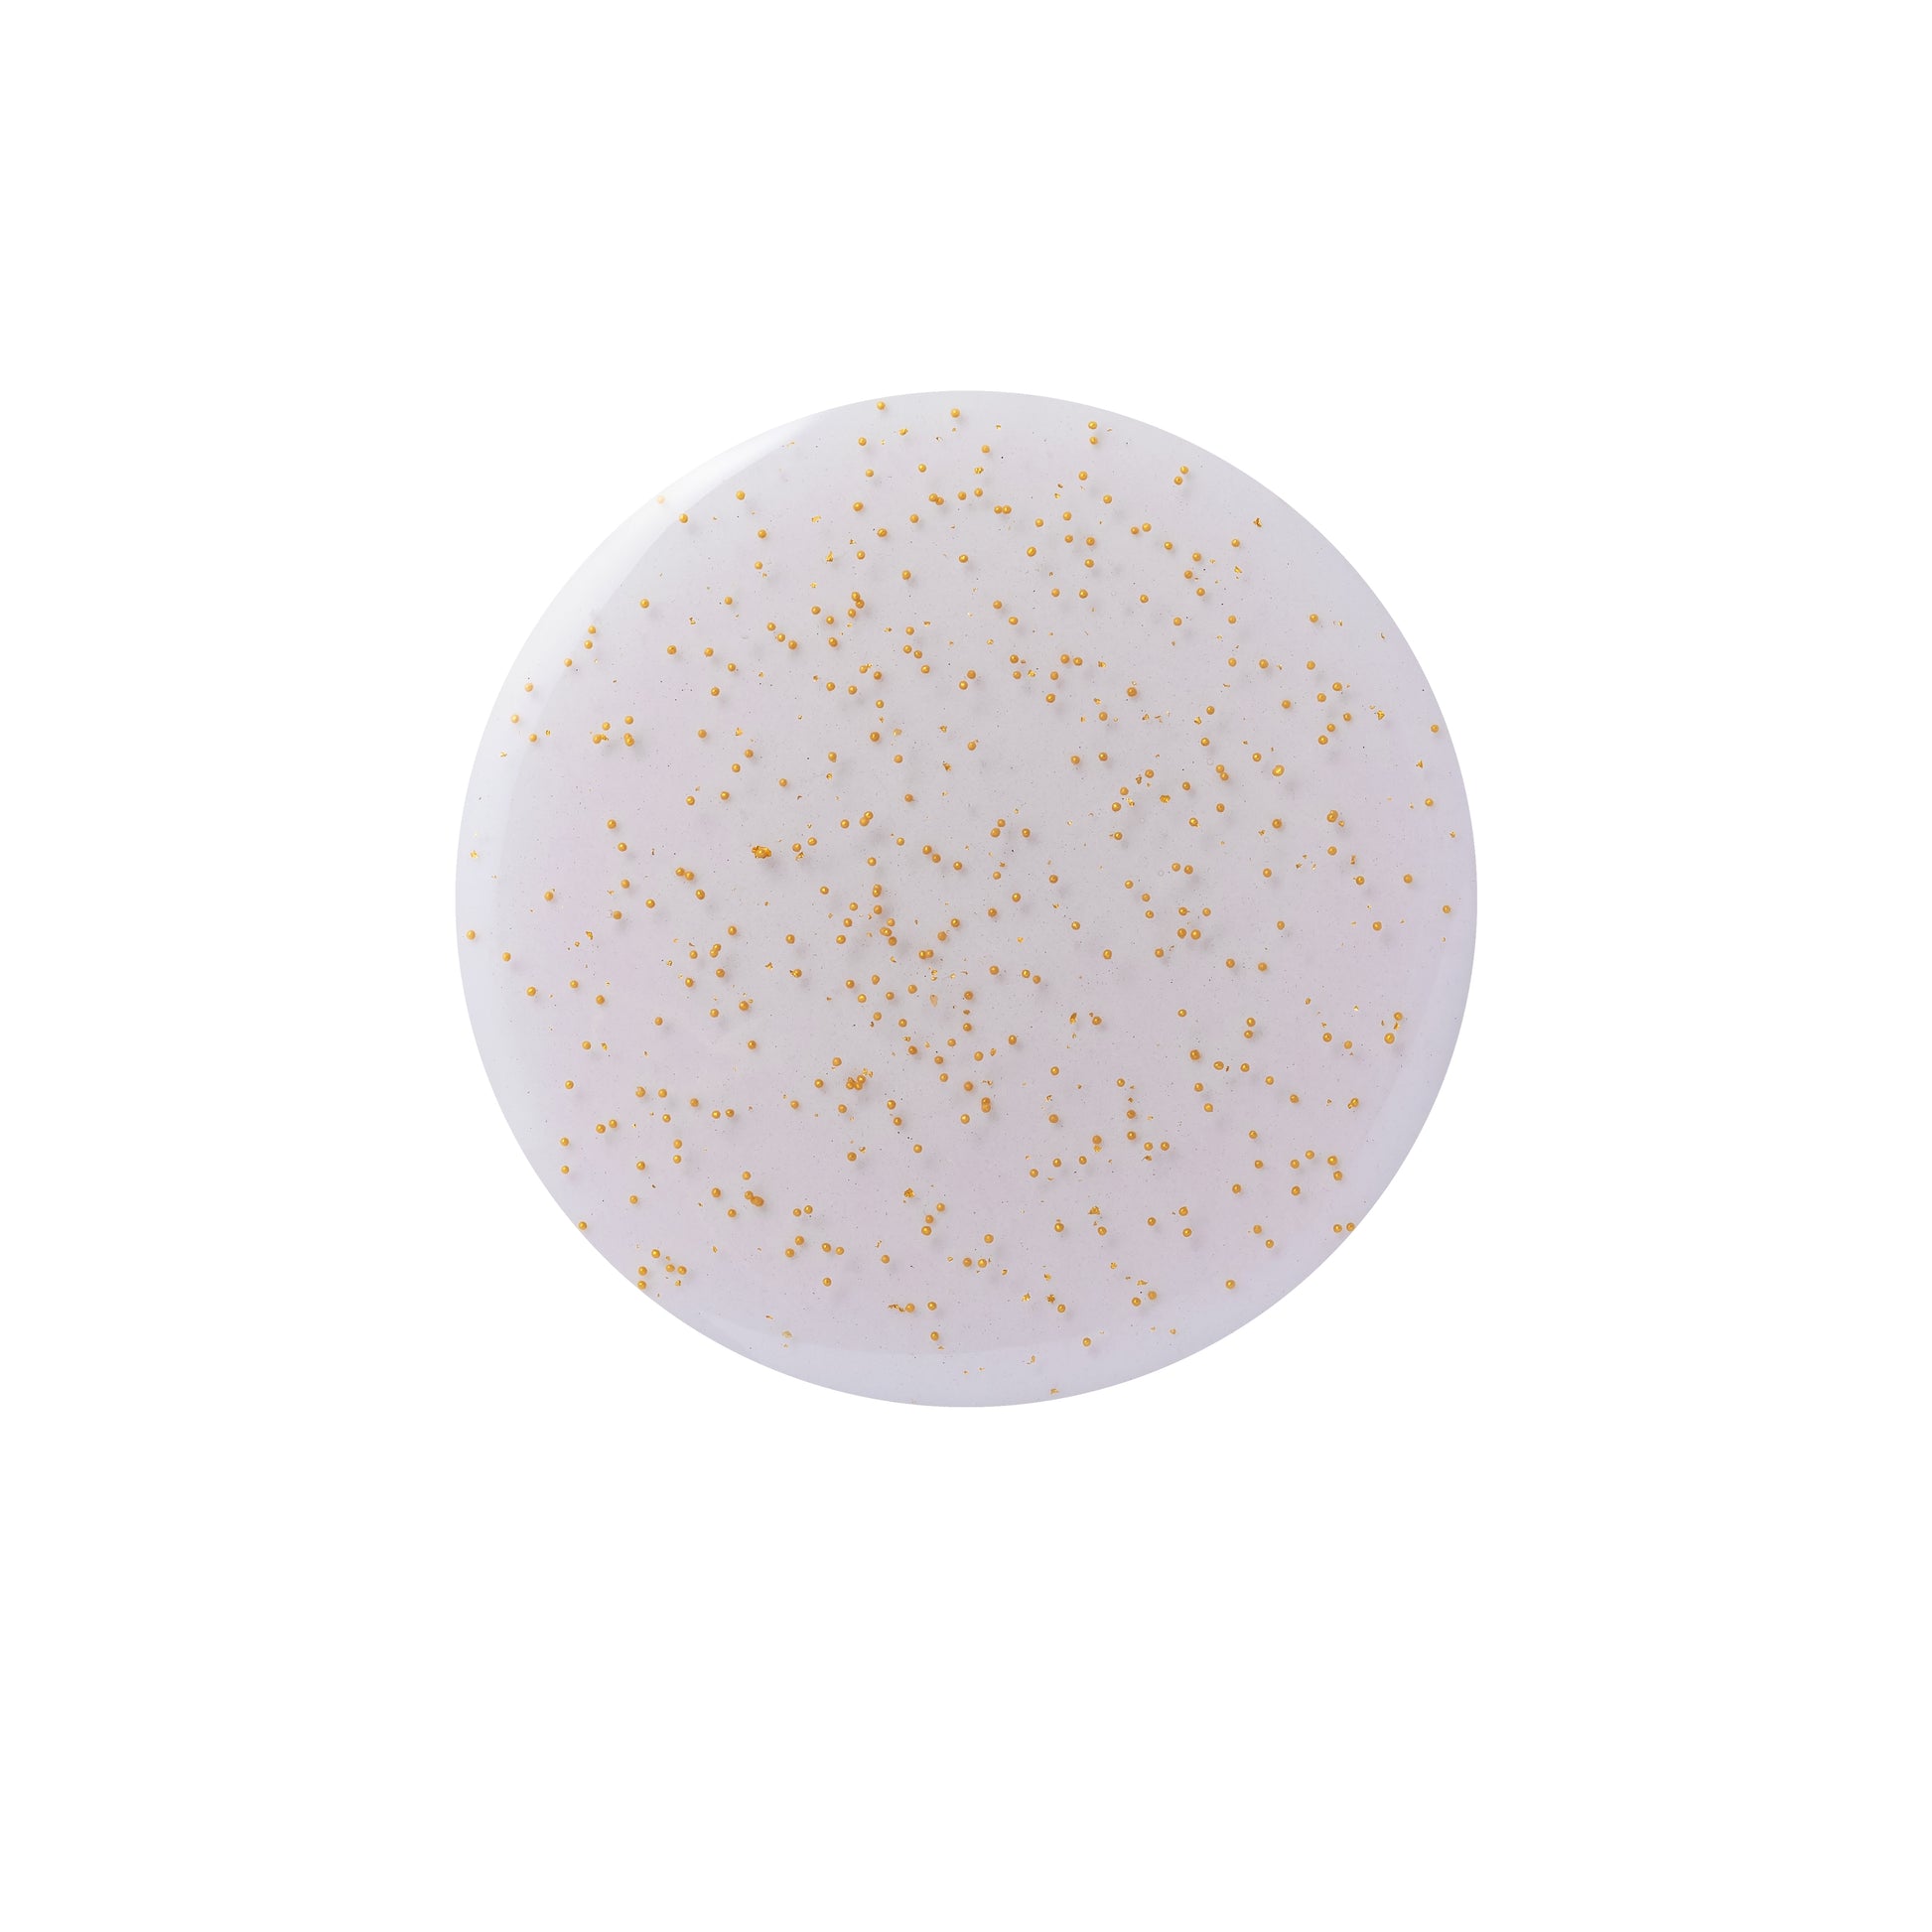

Trendilife
CODE 9 GOLD BLACK LIFTING ESSENCE 30ml
CODE 9 GOLD BLACK LIFTING ESSENCE 30ml
Couldn't load pickup availability
Elevate your skincare routine with the luxurious NEOGEN Code 9 Gold Black Lifting Essence — a premium anti-aging and revitalising essence designed to firm, smooth, and energise your skin. Formulated with real gold and powerful antioxidant complexes, this essence supports skin elasticity and delivers a radiant, youthful glow with every application.
Key Benefits
-Boosts Elasticity & Firmness: Helps improve skin firmness for a more lifted, youthful appearance.
-Radiance & Glow: Real gold and antioxidant-rich plant extracts revitalize dull, tired skin.
-Antioxidant Protection: 5-Black Antioxidant Complex helps defend against environmental stressors.
-Smooths & Nourishes: Enhances overall texture with nutrients from botanical extracts.
-Light, Non-Sticky Texture: Gel-like essence absorbs quickly without heaviness.
5-Black Antioxidant Complex: Plant extracts rich in polyphenols and anthocyanins that nourish and revitalise skin.
Patented COLLAGENEER & SYN-COLL: Supports collagen production for improved firmer-looking skin.
Plant Extract Blend: Multiple botanical extracts provide calming, hydrating and antioxidant benefits.
2.Smooth evenly over face and neck.
3.Gently pat until fully absorbed.
4.Follow with serum and moisturiser for best results.
5.Use morning and/or evening as part of your skincare routine.
Share